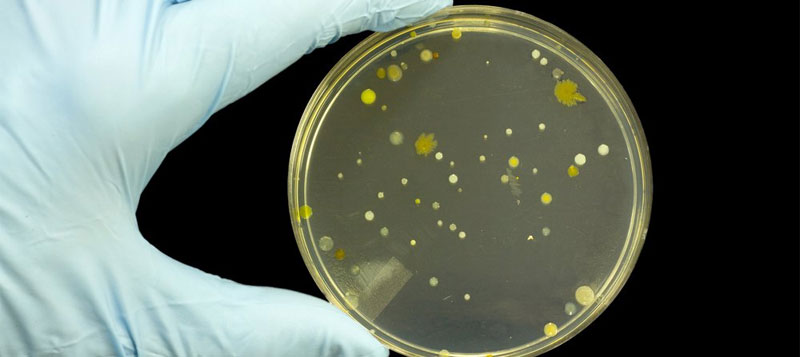

Coral Environmental Ltd Contact Details
Address
Unit B1 West Bank Drive,
Belfast
County Antrim
BT3 9LA
About Coral Environmental Ltd
Coral Environmental takes pride in providing real, common sense and cost effective solutions to our client’s needs and statutory requirements in today’s ever changing working environment.
Our company provides a full range consultancy services to private, commercial and industrial clients in areas including:
Legionella Management & Monitoring
An integral part of the ACOP’s requirements for the control of legionella bacteria is the need to undertake regular monitoring and checks on the systems to ensure that they are operating within the guideline parameters. Regular and routine checks such weekly flushing of infrequently used outlets, sentinel temperature monitoring, shower head descale and disinfection, maintenance and serving of thermostatic mixing valves and system inspections are required to ensure compliance with current regulations and guidelines.
Legionella Training
We offer a flexible range of training courses which include basic Legionella awareness, advanced Legionella Management, Manual Handling, Water Hygiene Blue Card and Health & Safety. Our training sessions are run at regular intervals and can be tailored to suit your specific company needs. Training can be delivered at your own premises, or at our offices in Belfast. There is no minimum delegate group size and we can offer 1 on 1 training if required.
Legionella Risk Assessment
What is Legionella?
Legionella bacteria are widespread in nature, mainly living in natural water systems, however, the conditions are rarely right for people to catch the disease from these sources.
Outbreaks of the illness occur from exposure to legionella bacteria growing in purpose built systems where the conditions are such that they encourage growth, e.g. dirt and heat within storage tanks, hot water cylinders, cooling towers, spa pools and hot water systems used in all sorts of premises (work and domestic).
Indoor Air Quality
Indoor air quality (IAQ) is a term which refers to the air quality within and around buildings and structures, especially as it relates to the health and comfort of building occupants.
IAQ can be affected by gases (including carbon monoxide, dioxide and radon), particulates, microbial contaminants (mould, bacteria). Source control, filtration and the use of ventilation to dilute contaminants are the primary methods for improving indoor air quality in most buildings.
The number of incidents associated with ill health, discomfort and nuisance in the indoor environment is increasing. This is occurring at the same time as the indoor environment is becoming more complex and more enclosed.
Get In Touch